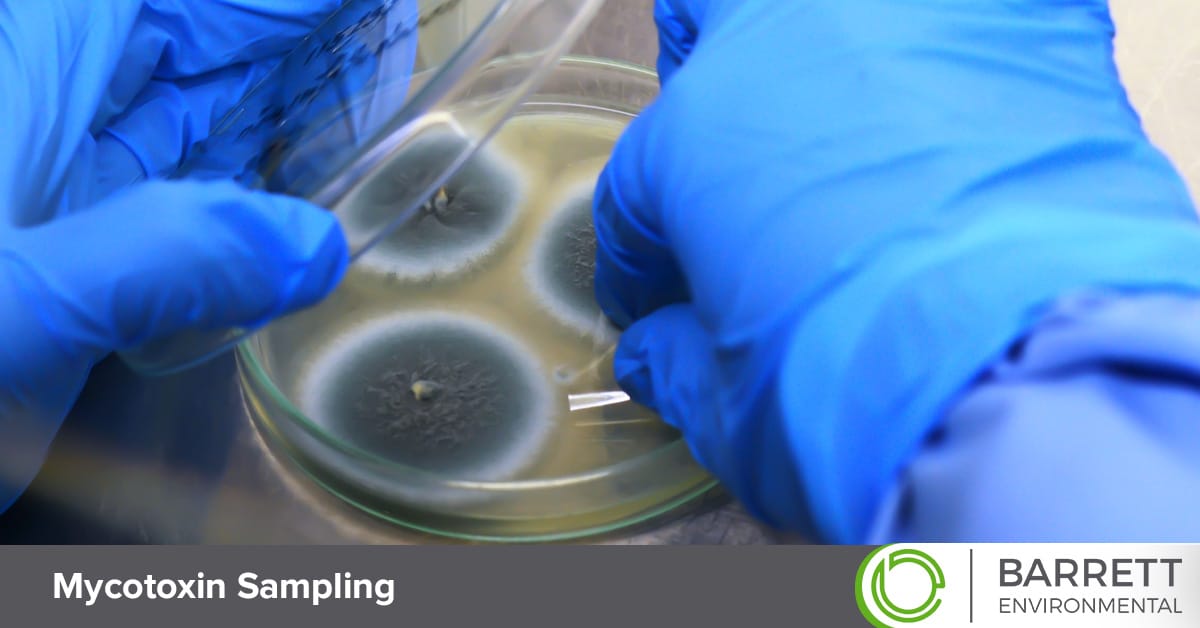
Dallas-Fort Worth mycotoxin sampling.

DFW Mycotoxin Sampling

Call Us Now (214) 886-3108
Home › Mold Testing Services › Dallas-Fort Worth Mycotoxin Sampling Service
Dallas-Fort Worth Professional Mycotoxin Sampling
Barrett Environmental provides expert mold inspections for homes and businesses across the Dallas-Fort Worth area. Backed by 45 years of combined industry experience, we offer comprehensive mycotoxin sampling services to identify hidden contamination. Mycotoxins are toxic substances produced by molds that can accumulate in indoor environments. With our precise mycotoxin sampling and analysis, clients receive science-backed data to address indoor air quality risks and guide effective remediation.
Advanced Mycotoxin Testing for Healthy Indoor Spaces
Mycotoxins are toxic compounds produced by mold species like Stachybotrys, Aspergillus, Penicillium and Fusarium. Unlike visible mold you can see, these toxins can be present in dust, air and surfaces even after mold is cleaned or removed. The effects of mycotoxins vary depending on a person’s sensitivity, but can include headaches, fatigue, asthma aggravation, respiratory issues and more.
At Barrett Environmental, we provide cutting-edge mold testing services and mycotoxin sampling where there is a potential risk. Our experienced inspectors collect air, dust or surface samples and send them to accredited laboratories that identify specific mycotoxins and measure their concentration levels.
Why Mycotoxin Sampling Is Needed
Indoor air quality may appear normal, but your environment could contain dangerous levels of mycotoxins that exceed safe exposure thresholds. Sampling is a recommended practice for these frequently-occurring events.
- After leaks, flooding and water damage and to verify cleanup effectiveness.
- For musty odors or visible signs of hidden moisture and dampness.
- Suffering persistent health symptoms or indoor air quality concerns without visible mold.
- When high-risk materials like drywall, insulation or carpet have been exposed to moisture.
- For a mold clearance inspection to confirm safe indoor air quality after remediation.
After sampling and lab analysis, we provide a detailed report identifying the specific mycotoxins, measured concentration levels, and the likely sources and problem areas in the building. With accurate data and recommendations, property owners and remediation companies can resolve these issues and restore safe, contaminant-free indoor spaces.
How Mycotoxin Sampling Helps Protect Your Property
Our mycotoxin sampling is guided by Ph.D.-level expertise in environmental science and supported by advanced diagnostic systems, delivering the accuracy and insight property owners need to address indoor air quality concerns. Whether you’ve recently experienced water intrusion, are buying, selling or leasing a property, or want to ensure the safety of residents or staff, expert mycotoxin sampling delivers precise data-driven information to guide your remediation strategy.
Common Questions About Mycotoxin Sampling
Does mycotoxin testing identify which areas of the building are most affected?
Mycotoxin testing of different areas, such as bedrooms, basements and HVAC systems, can identify where concentrations are highest. This approach will find the areas most affected, allowing for successful remediation.
How often should a property be tested for mycotoxins?
A property should typically be tested for mycotoxins when there is a specific concern, such as a water leak, flood damage, musty odors and mold issues. Routine testing is only necessary for buildings with a history of moisture problems.
Do I need mycotoxin testing after mold remediation is completed?
Post-remediation testing is recommended to verify that mycotoxin levels have returned to acceptable ranges and that the remediation was effective. With professional mycotoxin sampling, occupants and property owners can confirm that indoor spaces are safe and no longer a health risk.
Expert Mycotoxin Sampling in the Dallas-Fort Worth Area
Prevent mold exposure and remove mycotoxins from your home or business with the help of Barrett Environmental. Our cutting-edge testing and comprehensive remediation protocols ensure that properties are safe and free from hazardous mold. Call (214) 886-3108 or request an inspection today.